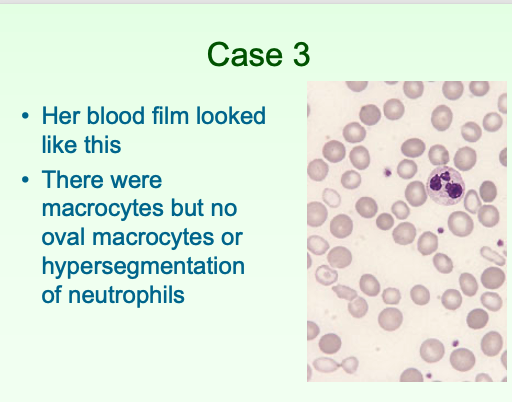

- A 5-year-old boy of Indian ethnic origin presented with lymphadenopathy and a mediastinal mass on chest radiology
- WBC 180 × 109/l, Hb 93 g/l and platelet count 43 × 109/l
- High (very high, so not infection) WCC a high WCC is bad prognostically
- Low Hb
- Low platelets
- What is the most likely diagnosis?
- What is the mediastinal mass?

- ALL
- •The very high WBC (180 × 109/l) in a child means a diagnosis of leukaemia is almost certain
- The low Hb (93 g/l) and platelet count (43 × 109/l) are the result of bone marrow infiltration
- The mediastinal mass is the thymus, which is infiltrated by T lymphoblasts
What would be the best technique to confirm the diagnosis?
- 1 Immunophenotyping
- 2 Cytochemistry
Immunophenotyping
What should be the follow-up in this child?
- The high WBC lessens the chance of cure but nevertheless there is a realistic chance of cure in this child
- He requires combination chemotherapy and CNS-directed therapy
- 48-year-old male – railway engineer
- 2-week history bleeding gums → attended dentist – severe bleeding
- 1 episode of haematuria and minor bruising
- Attended Accident and Emergency department
- Left subconjunctival haemorrhage Small bruises over abdomen
- No enlarged lymph nodes No hepatosplenomegaly

Blood count, film and coagulation screen
- Normal Renal function
- Minor liver derangement (longstanding)
- Alanine transaminase 97 iu/l (0‒37) HIGH
- Alkaline phosphatase 72 iu/l (30‒130) Normal
- Bilirubin 24 μmol/l (0‒17) HIGH
- FBC:
- WBC 7.5 × 109/l (4.0‒11) Normal
- Hb 109 g/l (130‒170) LOW
- MCV 83 fl (80-96) Normal/LOW
- Platelets 21 × 109/l (120‒400) LOW
- Coagulation screen:
- PT 13.4s (9.5-13.5) Normal
- APTT 21.5s (24-32) LOW
- Fibrinogen 0.97g/L (1.8-3.6) LOW
How would you explain a short APTT and a low fibrinogen? What other tests do you need?
Raises suspicion of a DIC (activated coagulation factors in circulation making APTT short) → do a D-dimer test to check…

- Granules strongly suggest myeloid
- Proof
–Cytochemistry
–Immunophenotyping
–But note that neither test is actually necessary

Acute promyelocytic leukaemia

Cytogenetic analysis etc
- This can be confirmed using cytogenetic analysis/FISH/molecular genetic analysis – n.b. you already know this is myeloid (Auer rods) so immunophenotyping is not too useful – now you want to determine APML from AML
- This will show the t (15;17) forming the PML-RARA fusion gene
What would the cytogenetic test show? How would you manage this patient? What would the prognosis be with tx?

- A 68-year-old retired secretary
- Gradual onset of fatigue, lethargy and exertional dyspnoea
- Non-smoker, not much alcohol, good diet
- On examination:
- Pallor (conjunctival and nail bed)
- Mild ankle oedema
- FBC:
- WBC 4.7 × 109/l (3.7–9.5) Normal
- Hb 76 g/l (115–150) LOW
- MCV 110 fl (82–98) HIGH
- Neutrophils 1.4 × 109/l (NR 1.7–6.1) LOW
- Platelet count 182 × 109/l (NR 145–350) Normal

Blood film
- Serum vitamin B12 — normal
- Red cell folate — normal
- Liver function tests — normal
- Thyroid function tests — normal
- Ferritin — 875 μg/l (normal range 20–200)
- N.B. this is probably not dangerous
•What do you suspect and what would you do next?
She has a dimorphic blood film
Suspect sideroblastic syndrome, BM aspirate
- Bone marrow aspirate
- 12% blast cells (normal < 5%)
- 45% of erythroblasts were ring sideroblasts

myelodysplastic syndrome (MDS) (MDS with excess of blasts)
What would the management be? What is the prognosis of this?

The ferritin was 875 μg/l (NR 20–200) Why?
Does it matter?
1 Yes
2 No
3 Probably not
Probably not - predicted survival not many years so ferritin won’t rise to a point where it would be significant
- A 72-year-old Indian woman
- Vegetarian, teetotal, non-smoker
- SOBOE, fatigue
- Painful gums and tongue, unable to eat spicy food
- On examination: pallor only
- Test results:
- WBC and platelets normal
- Hb 52 g/L
- MCV 122 fl
What is the most important test?

- Hypersegmented neutrophils (so, measure vitamin B12 and folate)
- Tear drop poikilocytosis
- Oval macrocytes

BM aspirate
Do you think the patient has a myelodysplastic syndrome?
1 Yes
2 No

No
- Parietal cell antibodies: positive
- Intrinsic factor antibodies: positive
- The patient turned out to be a vegan
- You should now know the correct diagnosis and be able to explain how you would treat the patient

- 70yo woman referred to vascular surgeon due to gangrenous toes
- Non-diabetic, 50-pack-year history
- SOBOE and morning cough
- On examination:
- Reduced femoral and distal pulses on side of affected toes
- Not breathless at rest, no cyanosis
- Plethora, conjunctival suffusion
- Spleen not felt
What simple test would you do first?
FBC, blood gas

Polycythaemia vera

Molecular analysis for JAK2 mutation

Venesection plus hydroxycarbamide

This would be unsuitable alone as it will not reduce the platelet count


